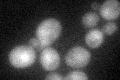
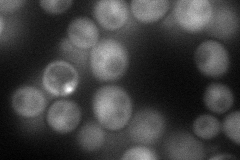
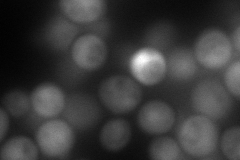
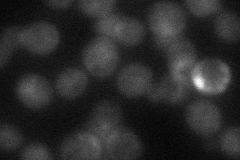
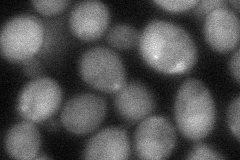
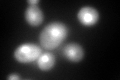
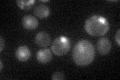

View description
Serine/threonine MAP kinase involved in regulating the maintenance of cell wall integrity and progression through the cell cycle; regulated by the PKC1-mediated signaling pathway
Localization:
Intensity:
Fold change:
Significance:
-
C’ GFP library in SD
nucleus:cytosol38.49 -
N' NOP1pr-GFP in SD
cytosol,nucleus81.2547 -
N' TEF2pr-mCherry in SD
cytosol,nucleus154.887 -
N' NATIVEpr-GFP in SD
cytosol,nucleus34.3644 -
N' TEF2pr-VC and Cyto-VN in SD
cytosol50.2507 -
C’ GFP library in SD+DTT
nucleus.cytosol132.733.44Yes -
C’ GFP library in SD+H2O2

nucleus.cytosol36.810.95No -
C’ GFP library in Starvation Media
nucleus,cytosol44.061.14No -
C’ GFP library on the background of Pup2-DaMP

nucleus:cytosol -
C’ GFP library on the background of CCT mutant

nucleus:cytosol56.76231.47434Yes
